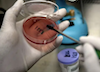
微生物检测中常用的细菌接种方法汇总！

厦门大学化学化工学院汪骋教授课题组与数学学院周达副教授课题组利用机器学习发现CO2还原的C......
草芽圈 > 培养基
-
厦大汪骋/周达JACS:合作利用机器学习指导CO2还原的Cu基催化剂的制备
-
微生物检测中常用的细菌接种方法汇总!
常用的细菌接种方法有平板划线分离法、斜面接种法、穿刺接种法、液体和半固体接种法、涂布接种法......
没有更多内容